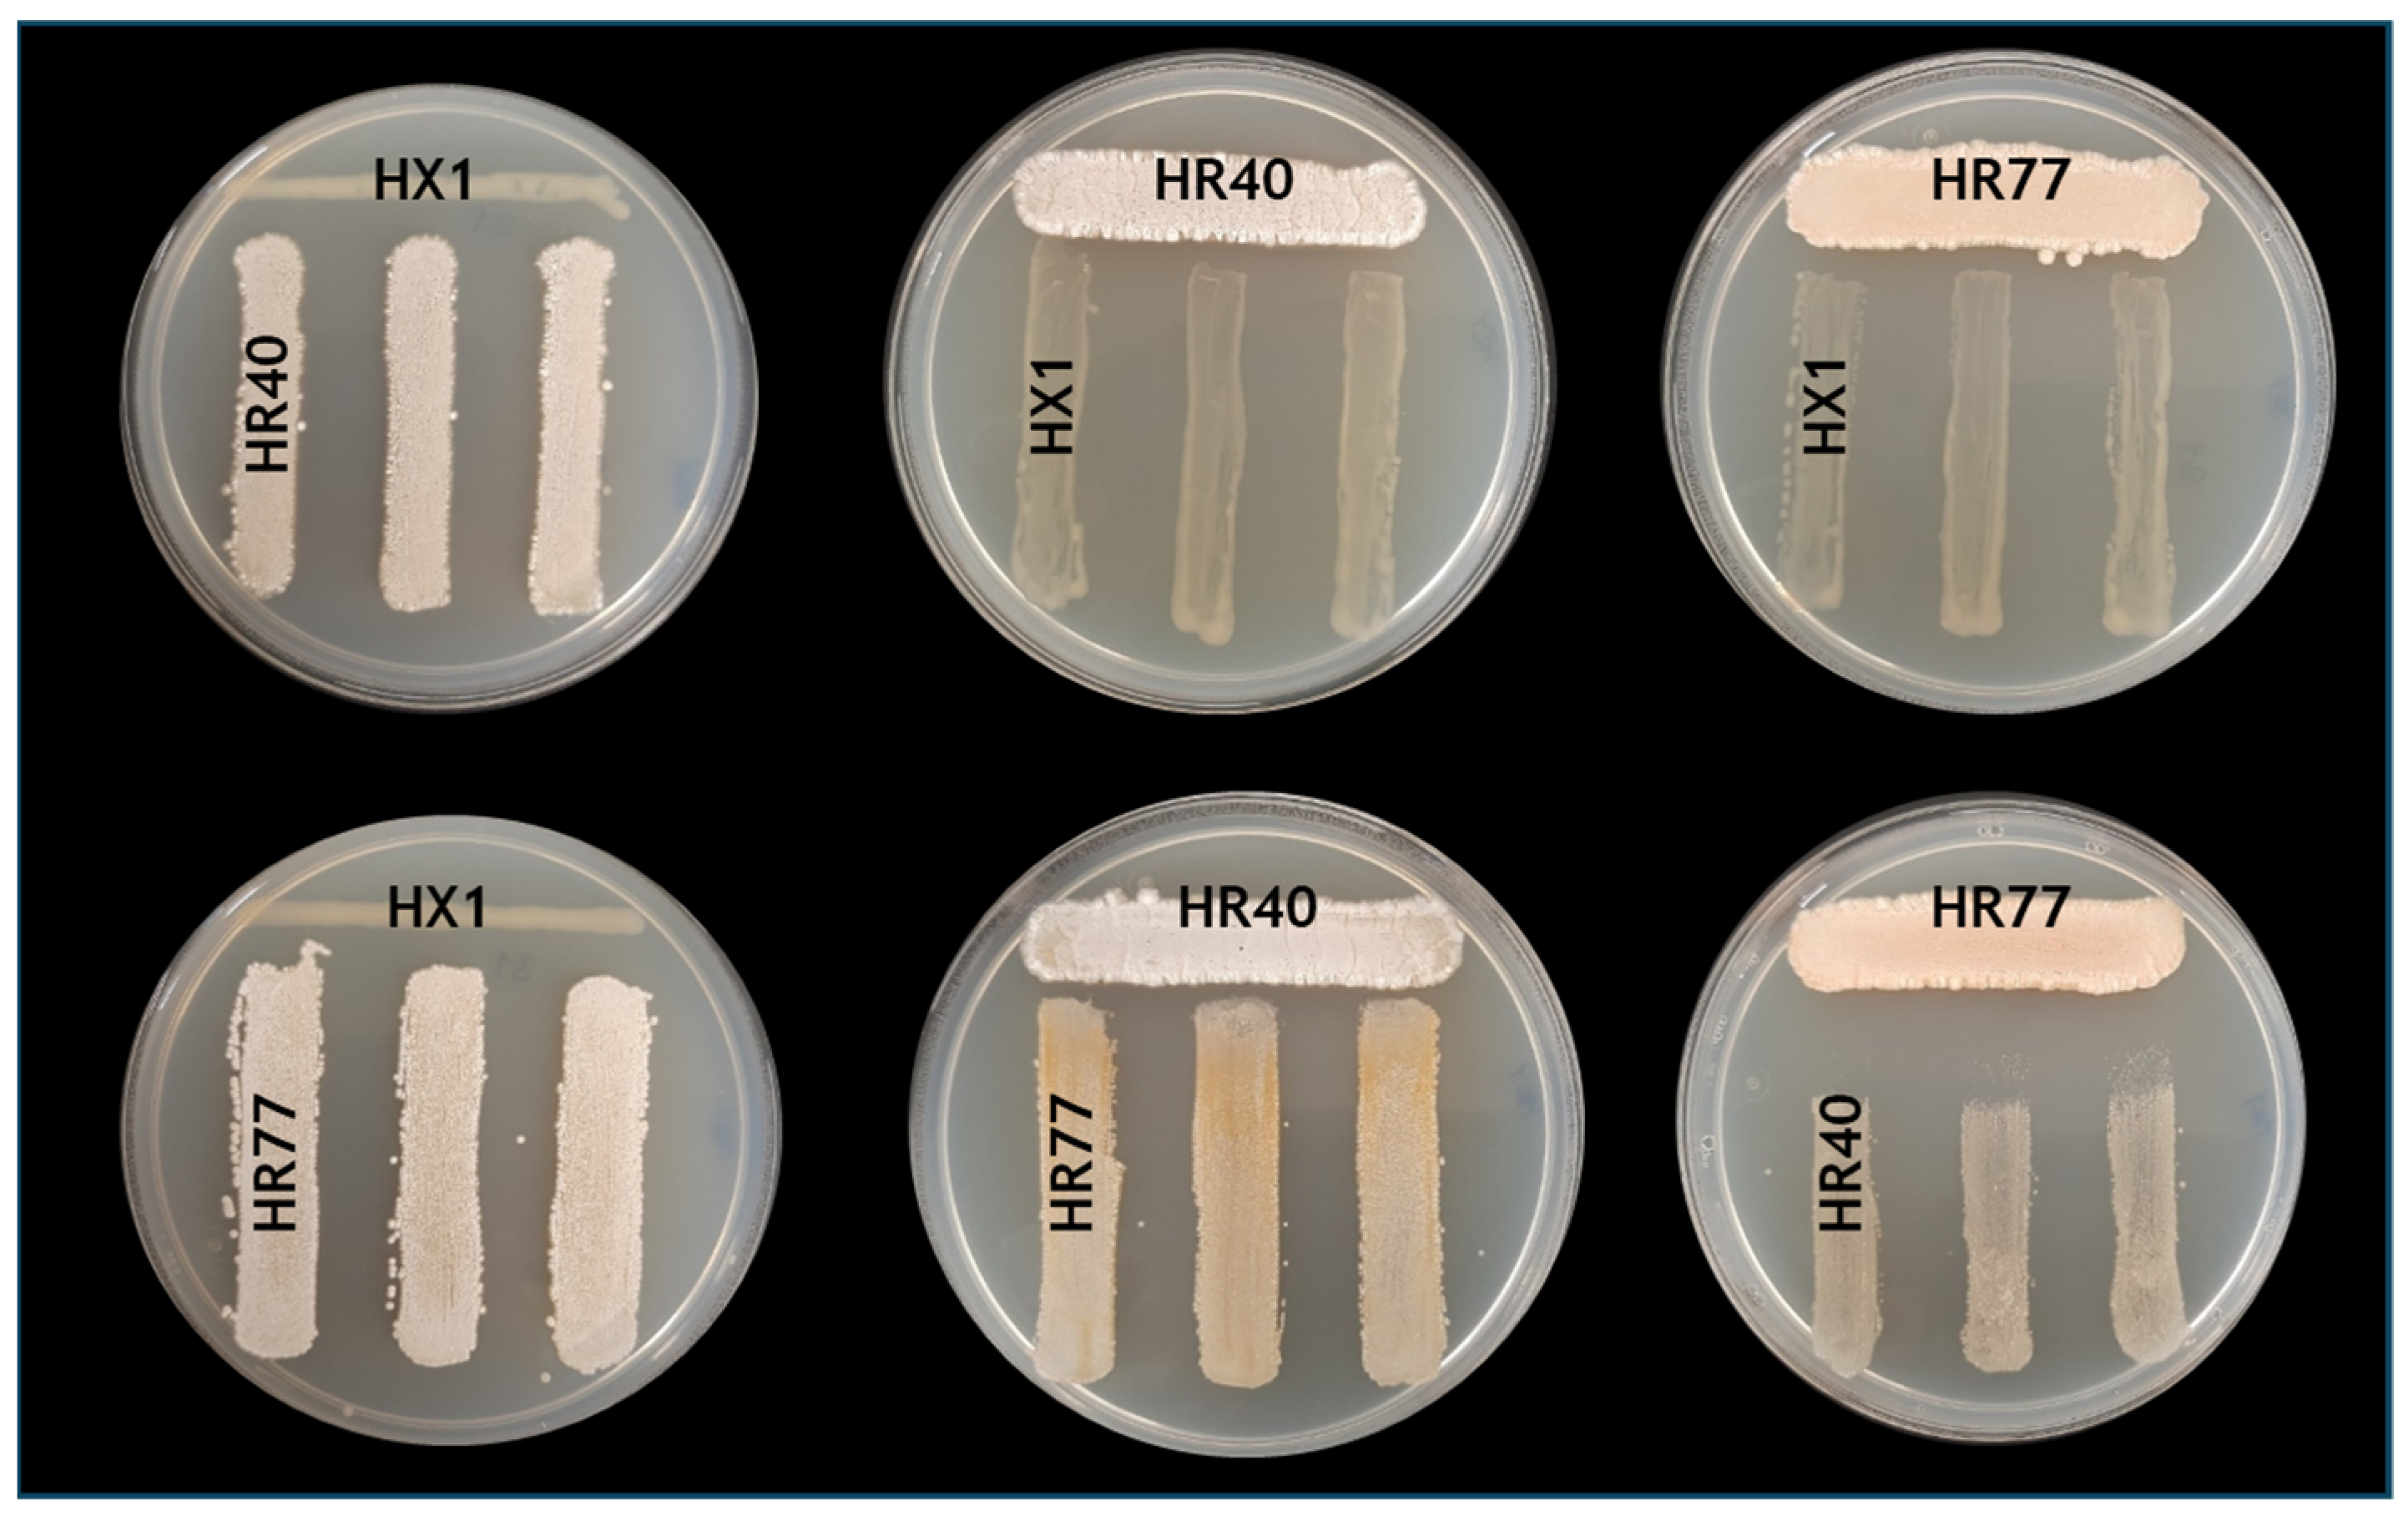
Horticulturae 11 00459 g004

Isolation and Characterization of Pseudomonas sp. HX1, Streptomyces luteogriseus HR40, and Streptomyces flavofungini HR77 as Promising Biocontrol Agents Against Verticillium Wilt in Hops Affected by Verticillium nonalfalfae
Abstract
1. Introduction
2. Materials and Methods
2.1. Isolation of Culturable Streptomycetes Strains from the Rhizosphere of Hop Plants
2.2. Isolation of Culturable Streptomycetes from the Endosphere of Hop Roots
2.3. Isolation of Culturable Bacterial Strains from the Xylem of Hop Plants
2.4. In Vitro Selection of Isolates Based on Antifungal Activity in Plate Assays
2.5. Preliminary Identification of Bacterial Strains by 16S rRNA and rpoD Gene Sequencing
2.6. Identification of Streptomyces Isolates Through Multilocus Sequence Analysis (MLSA)
2.7. Genome Sequencing and Biosynthetic Gene Cluster Analysis
2.8. Plant Assays to Evaluate the Effectiveness of Selected Bacterial Isolates Against Verticillium Wilt Caused by V. nonalfalfae
2.9. Confrontation Assays
2.10. Analysis of AF Activity in Small-Scale Soil Tests
2.11. Soil Physicochemical Properties
2.12. Statystical Analysis
3. Results
3.1. Isolation of Culturable Streptomycetes from the Root System and Other Endophytic Bacterial Strains from the Xylem of Hop Plants and Their Antifungal Activity
3.2. Molecular Identification of the Selected Isolates by Partial Sequencing of 16S rRNA and rpoD Genes and Multilocus Sequence Analysis (MLSA)
3.3. Genome Analysis of Streptomyces Flavofungini HR77 Strain
3.4. Genome Analysis of Streptomyces luteogriseus DSM 40483 Type Strain
3.5. Genome Analysis of Streptomyces sirii HR31 Strain
3.6. In Planta Efficacy of Selected Bacterial Isolates Against Verticillium Wilt Caused by V. nonalfalfae
3.7. Strain-Specific Patterns of Inhibition in Interaction Bioassays
3.8. Analysis of the Antifungal Activity of the Selected Strains in Small-Scale Soil Tests
4. Discussion
5. Conclusions
Supplementary Materials
Author Contributions
Funding
Data Availability Statement
Acknowledgments
Conflicts of Interest
References
- González-Salitre, L.; Guillermo González-Olivares, L.; Antobelli Basilio-Cortes, U. Humulus lupulus L. a Potential Precursor to Human Health: High Hops Craft Beer. Food Chem. 2023, 405, 134959. [Google Scholar] [CrossRef] [PubMed]
- Gerhäuser, C. Broad Spectrum Antiinfective Potential of Xanthohumol from Hop (Humulus lupulus L.) in Comparison with Activities of Other Hop Constituents and Xanthohumol Metabolites. Mol. Nutr. Food Res. 2005, 49, 827–831. [Google Scholar] [CrossRef]
- Stevens, J.F.; Page, J.E. Xanthohumol and Related Prenylflavonoids from Hops and Beer: To Your Good Health! Phytochemistry 2004, 65, 1317–1330. [Google Scholar] [CrossRef]
- International Hop Growers’ Convention Economic Commission—Summary Reports; IHGC-Economic Commission: Lublin, Poland, 2024; Available online: https://www.ihgc.org/activities/lublin-poland/ (accessed on 20 April 2025).
- Neve, R.A. Hops; Springer: Dordrecht, The Netherlands, 1991; ISBN 978-94-010-5375-4. [Google Scholar]
- Radisek, S. Verticillium Wilt. In Compendium of Hop Diseases and Arthropod Pests; Mahaffee, W.F., Pethybridge, S.J., Gent, D.H., Eds.; APS Press the American Phytopathological Society: St. Paul, MN, USA, 2009; pp. 33–36. [Google Scholar]
- Gent, D.H.; Woods, J.L.; Putnam, M.L. New Outbreaks of Verticillium Wilt on Hop in Oregon Caused by Nonlethal Verticillium albo-atrum. Plant Health Prog. 2012, 13, 14. [Google Scholar] [CrossRef]
- Compant, S.; Duffy, B.; Nowak, J.; Clément, C.; Barka, E.A. Use of Plant Growth-Promoting Bacteria for Biocontrol of Plant Diseases: Principles, Mechanisms of Action, and Future Prospects. Appl. Environ. Microbiol. 2005, 71, 4951–4959. [Google Scholar] [CrossRef]
- Lugtenberg, B.; Kamilova, F. Plant-Growth-Promoting Rhizobacteria. Annu. Rev. Microbiol. 2009, 63, 541–556. [Google Scholar] [CrossRef]
- Carrero-Carrón, I.; Trapero-Casas, J.L.; Olivares-García, C.; Monte, E.; Hermosa, R.; Jiménez-Díaz, R.M. Trichoderma asperellum Is Effective for Biocontrol of Verticillium Wilt in Olive Caused by the Defoliating Pathotype of Verticillium dahliae. Crop Prot. 2016, 88, 45–52. [Google Scholar] [CrossRef]
- Varo, A.; Raya-Ortega, M.C.; Trapero, A. Selection and Evaluation of Micro-Organisms for Biocontrol of Verticillium dahliae in Olive. J. Appl. Microbiol. 2016, 121, 767–777. [Google Scholar] [CrossRef]
- Lozano-Tovar, M.D.; Garrido-Jurado, I.; Quesada-Moraga, E.; Raya-Ortega, M.C.; Trapero-Casas, A. Metarhizium brunneum and Beauveria bassiana Release Secondary Metabolites with Antagonistic Activity against Verticillium dahliae and Phytophthora megasperma Olive Pathogens. Crop Prot. 2017, 100, 186–195. [Google Scholar] [CrossRef]
- Mulero-Aparicio, A.; Agustí-Brisach, C.; Varo, Á.; López-Escudero, F.J.; Trapero, A. A Non-Pathogenic Strain of Fusarium oxysporum as a Potential Biocontrol Agent against Verticillium Wilt of Olive. Biol. Control 2019, 139, 104045. [Google Scholar] [CrossRef]
- Mulero-Aparicio, A.; Cernava, T.; Turrà, D.; Schaefer, A.; Di Pietro, A.; López-Escudero, F.J.; Trapero, A.; Berg, G. The Role of Volatile Organic Compounds and Rhizosphere Competence in Mode of Action of the Non-Pathogenic Fusarium oxysporum FO12 Toward Verticillium Wilt. Front. Microbiol. 2019, 10, 468375. [Google Scholar] [CrossRef] [PubMed]
- Markakis, E.A.; Tjamos, S.E.; Antoniou, P.P.; Paplomatas, E.J.; Tjamos, E.C. Biological Control of Verticillium Wilt of Olive by Paenibacillus alvei, Strain K165. BioControl 2016, 61, 293–303. [Google Scholar] [CrossRef]
- Cabanás, C.G.L.; Sesmero, R.; Valverde-Corredor, A.; Javier López-Escudero, F.; Mercado-Blanco, J. A Split-Root System to Assess Biocontrol Effectiveness and Defense-Related Genetic Responses in above-Ground Tissues during the Tripartite Interaction Verticillium dahliae-Olive-Pseudomonas fluorescens PICF7 in Roots. Plant Soil. 2017, 417, 433–452. [Google Scholar] [CrossRef]
- Gómez-Lama Cabanás, C.; Legarda, G.; Ruano-Rosa, D.; Pizarro-Tobías, P.; Valverde-Corredor, A.; Niqui, J.L.; Triviño, J.C.; Roca, A.; Mercado-Blanco, J. Indigenous Pseudomonas spp. Strains from the Olive (Olea europaea L.) Rhizosphere as Effective Biocontrol Agents against Verticillium dahliae: From the Host Roots to the Bacterial Genomes. Front. Microbiol. 2018, 9, 297478. [Google Scholar] [CrossRef]
- Cheffi Azabou, M.; Gharbi, Y.; Medhioub, I.; Ennouri, K.; Barham, H.; Tounsi, S.; Triki, M.A. The Endophytic Strain Bacillus Velezensis OEE1: An Efficient Biocontrol Agent against Verticillium Wilt of Olive and a Potential Plant Growth Promoting Bacteria. Biol. Control 2020, 142, 104168. [Google Scholar] [CrossRef]
- Calvo-Peña, C.; Cobos, R.; Sánchez-López, J.M.; Ibañez, A.; Coque, J.J.R. Albocycline Is the Main Bioactive Antifungal Compound Produced by Streptomyces sp. OR6 against Verticillium dahliae. Plants 2023, 12, 3612. [Google Scholar] [CrossRef]
- Zeng, Q.; Man, X.; Dai, Y.; Liu, H. Pseudomonas spp. Enriched in Endophytic Community of Healthy Cotton Plants Inhibit Cotton Verticillium Wilt. Front. Microbiol. 2022, 13, 906732. [Google Scholar] [CrossRef] [PubMed]
- Bubici, G. Streptomyces spp. as Biocontrol Agents against Fusarium Species. CABI Rev. 2018, 13, 1–15. [Google Scholar] [CrossRef]
- Labeda, D.P.; Goodfellow, M.; Brown, R.; Ward, A.C.; Lanoot, B.; Vanncanneyt, M.; Swings, J.; Kim, S.B.; Liu, Z.; Chun, J.; et al. Phylogenetic Study of the Species within the Family Streptomycetaceae. Antonie Van Leeuwenhoek 2012, 101, 73–104. [Google Scholar] [CrossRef]
- van der Meij, A.; Worsley, S.F.; Hutchings, M.I.; van Wezel, G.P. Chemical Ecology of Antibiotic Production by Actinomycetes. FEMS Microbiol. Rev. 2017, 41, 392–416. [Google Scholar] [CrossRef]
- Vurukonda, S.S.K.P.; Giovanardi, D.; Stefani, E. Plant Growth Promoting and Biocontrol Activity of Streptomyces spp. as Endophytes. Int. J. Mol. Sci. 2018, 19, 952. [Google Scholar] [CrossRef]
- Janssen, P.H. Identifying the Dominant Soil Bacterial Taxa in Libraries of 16S RRNA and 16S RRNA Genes. Appl. Environ. Microbiol. 2006, 72, 1719–1728. [Google Scholar] [CrossRef] [PubMed]
- Deketelaere, S.; Tyvaert, L.; França, S.C.; Hofte, M. Desirable Traits of a Good Biocontrol Agent against Verticillium Wilt. Front. Microbiol. 2017, 8, 1186. [Google Scholar] [CrossRef] [PubMed]
- Bacon, C.W.; Hinton, D.M. Bacterial Endophytes: The Endophytic Niche, Its Occupants, and Its Utility. In Plant-Associated Bacteria; Springer: Berling, Germany, 2007; pp. 155–194. [Google Scholar] [CrossRef]
- Ali, M.A.; Ahmed, T.; Ibrahim, E.; Rizwan, M.; Chong, K.P.; Yong, J.W.H. A Review on Mechanisms and Prospects of Endophytic Bacteria in Biocontrol of Plant Pathogenic Fungi and Their Plant Growth-Promoting Activities. Heliyon 2024, 10, e31573. [Google Scholar] [CrossRef]
- Küster, E.; Williams, S.T. Selection of Media for Isolation of Streptomycetes. Nature 1964, 202, 928–929. [Google Scholar] [CrossRef] [PubMed]
- Shirling, E.B.; Gottlieb, D. Methods for Characterization of Streptomyces Species. Int. J. Syst. Bacteriol. 1966, 16, 313–340. [Google Scholar] [CrossRef]
- Kieser, T.; Bibb, M.J.; Buttner, M.J.; Chater, K.F.; Hopwood, D.A. Practical Streptomyces Genetics; John Innes Foundation: Norwich, UK, 2000; ISBN 0708406238. [Google Scholar]
- Álvarez-Pérez, J.M.; González-García, S.; Cobos, R.; Olego, M.Á.; Ibañez, A.; Díez-Galán, A.; Garzón-Jimeno, E.; Coque, J.J.R. Use of Endophytic and Rhizosphere Actinobacteria from Grapevine Plants to Reduce Nursery Fungal Graft Infections That Lead to Young Grapevine Decline. Appl. Environ. Microbiol. 2017, 83, e01564-17. [Google Scholar] [CrossRef]
- Radišek, S.; Jakše, J.; Javornik, B. Genetic Variability and Virulence among Verticillium albo-atrum Isolates from Hop. Eur. J. Plant Pathol. 2006, 116, 301–314. [Google Scholar] [CrossRef]
- Hopwood, D.A.; Bibb, M.J.; Chater, K.F.; Kieser, T.; Bruton, C.J.; Kieser, H.M.; Lydiate, D.J.; Smith, C.P.; Ward, J.M.; Schrempf, H. Genetic Manipulation of Streptomyces: A Laboratory Manual; The John Innes Institute: Norwich, UK, 1985. [Google Scholar]
- Lane, D.J. 16S/23S RRNA Sequencing. In Nucleic Acid Techniques in Bacterial Systematics; Stackebrandt, E., Goodfellow, M., Eds.; John Wiley and Sons: New York, NY, USA, 1991. [Google Scholar]
- Kim, O.S.; Cho, Y.J.; Lee, K.; Yoon, S.H.; Kim, M.; Na, H.; Park, S.C.; Jeon, Y.S.; Lee, J.H.; Yi, H.; et al. Introducing EzTaxon-e: A Prokaryotic 16s RRNA Gene Sequence Database with Phylotypes That Represent Uncultured Species. Int. J. Syst. Evol. Microbiol. 2012, 62, 716–721. [Google Scholar] [CrossRef]
- Girard, L.; Lood, C.; Rokni-Zadeh, H.; van Noort, V.; Lavigne, R.; De Mot, R. Reliable Identification of Environmental Pseudomonas Isolates Using the rpoD Gene. Microorganisms 2020, 8, 1166. [Google Scholar] [CrossRef]
- Rong, X.; Huang, Y. Taxonomic Evaluation of the Streptomyces hygroscopicus Clade Using Multilocus Sequence Analysis and DNA–DNA Hybridization, Validating the MLSA Scheme for Systematics of the Whole Genus. Syst. Appl. Microbiol. 2012, 35, 7–18. [Google Scholar] [CrossRef] [PubMed]
- Guo, Y.P.; Zheng, W.; Rong, X.Y.; Huang, Y. A Multilocus Phylogeny of the Streptomyces griseus 16S RRNA Gene Clade: Use of Multilocus Sequence Analysis for Streptomycete Systematics. Int. J. Syst. Evol. Microbiol. 2008, 58, 149–159. [Google Scholar] [CrossRef] [PubMed]
- Rong, X.; Guo, Y.; Huang, Y. Proposal to Reclassify the Streptomyces albidoflavus Clade on the Basis of Multilocus Sequence Analysis and DNA–DNA Hybridization, and Taxonomic Elucidation of Streptomyces griseus Subsp. solvifaciens. Syst. Appl. Microbiol. 2009, 32, 314–322. [Google Scholar] [CrossRef]
- Tamura, K.; Stecher, G.; Kumar, S. MEGA11: Molecular Evolutionary Genetics Analysis Version 11. Mol. Biol. Evol. 2021, 38, 3022–3027. [Google Scholar] [CrossRef] [PubMed]
- Kimura, M. A Simple Method for Estimating Evolutionary Rates of Base Substitutions through Comparative Studies of Nucleotide Sequences. J. Mol. Evol. 1980, 16, 111–120. [Google Scholar] [CrossRef]
- Koren, S.; Walenz, B.P.; Berlin, K.; Miller, J.R.; Bergman, N.H.; Phillippy, A.M. Canu: Scalable and Accurate Long-Read Assembly via Adaptive k-Mer Weighting and Repeat Separation. Genome Res. 2017, 27, 722–736. [Google Scholar] [CrossRef]
- Mikheenko, A.; Prjibelski, A.; Saveliev, V.; Antipov, D.; Gurevich, A. Versatile Genome Assembly Evaluation with QUAST-LG. Bioinformatics 2018, 34, i142–i150. [Google Scholar] [CrossRef]
- Overbeek, R.; Olson, R.; Pusch, G.D.; Olsen, G.J.; Davis, J.J.; Disz, T.; Edwards, R.A.; Gerdes, S.; Parrello, B.; Shukla, M.; et al. The SEED and the Rapid Annotation of Microbial Genomes Using Subsystems Technology (RAST). Nucleic Acids Res. 2014, 42, D206–D214. [Google Scholar] [CrossRef]
- Meier-Kolthoff, J.P.; Auch, A.F.; Klenk, H.-P.; Göker, M. Genome Sequence-Based Species Delimitation with Confidence Intervals and Improved Distance Functions. BMC Bioinform. 2013, 14, 60. [Google Scholar] [CrossRef]
- Meier-Kolthoff, J.P.; Göker, M. TYGS Is an Automated High-Throughput Platform for State-of-the-Art Genome-Based Taxonomy. Nat. Commun. 2019, 10, 2182. [Google Scholar] [CrossRef]
- Blin, K.; Shaw, S.; Augustijn, H.E.; Reitz, Z.L.; Biermann, F.; Alanjary, M.; Fetter, A.; Terlouw, B.R.; Metcalf, W.W.; Helfrich, E.J.N.; et al. AntiSMASH 7.0: New and Improved Predictions for Detection, Regulation, Chemical Structures and Visualisation. Nucleic Acids Res. 2023, 51, W46–W50. [Google Scholar] [CrossRef]
- Flajšman, M.; Radišek, S.; Javornik, B. Pathogenicity Assay of Verticillium nonalfalfae on Hop Plants. Bio-Protocol 2017, 7, e2171. [Google Scholar] [CrossRef]
- Brglez, A.; Devetak, Z.; Ogris, N.; Radišek, S.; Piškur, B. An Outbreak of Verticillium dahliae on Sycamore Maple in a Forest Stand in Slovenia. J. Plant Pathol. 2024, 106, 609–621. [Google Scholar] [CrossRef]
- Schrey, S.D.; Erkenbrack, E.; Früh, E.; Fengler, S.; Hommel, K.; Horlacher, N.; Schulz, D.; Ecke, M.; Kulik, A.; Fiedler, H.P.; et al. Production of Fungal and Bacterial Growth Modulating Secondary Metabolites Is Widespread among Mycorrhiza-Associated Streptomycetes. BMC Microbiol. 2012, 12, 164. [Google Scholar] [CrossRef] [PubMed]
- International Organization for Standardization. ISO 11277:2020—Soil Quality—Determination of Particle Size Distribution in Mineral Soil Material—Method by Sieving and Sedimentation. 2020. Available online: https://www.iso.org/standard/69496.html (accessed on 20 April 2025).
- Tan, K.H. Soil Sampling, Preparation, and Analysis. In Soil Sampling, Preparation, and Analysis; CRC Press: Boca Raton, FL, USA, 2005. [Google Scholar] [CrossRef]
- Batjes, N.H. Total Carbon and Nitrogen in the Soils of the World. Eur. J. Soil Sci. 1996, 47, 151–163. [Google Scholar] [CrossRef]
- Olsen, S.R.; Dean, L.A. Phosphorus. In Methods of Soil Analysis, Part 2: Chemical and Microbiological Properties; Wiley: Hoboken, NJ, USA, 2016; pp. 1035–1049. [Google Scholar]
- Ostrowska, A.; Gawliński, S.; Szczubiałka, Z. Methods of Analysis and Assessment of Soil and Plant Properties; Instytut Ochrony Środowiska: Warsaw, Poland, 1991. [Google Scholar]
- Houba, V.J.G.; Temminghoff, E.J.M.; Gaikhorst, G.A.; van Vark, W. Soil Analysis Procedures Using 0.01 M Calcium Chloride as Extraction Reagent. Commun. Soil Sci. Plant Anal. 2000, 31, 1299–1396. [Google Scholar] [CrossRef]
- Association Française de Normalisation. NF X31-122:1999—Soil Quality—Measurement of the Aerobic Biological Activity of Soil—Respirometric Method with Oxygen Measurement. 1999. Available online: https://www.dinmedia.de/en/standard/nf-x31-122/23265586 (accessed on 20 April 2025).
- Slovenian Institute for Standardization. SIST ISO 14235:1999—Soil Quality—Determination of Organic Carbon by Sulfochromic Oxidation. 1999. Available online: https://standards.iteh.ai/catalog/standards/sist/215eea8b-6056-4b77-942d-e4907c003860/sist-iso-14235-1999 (accessed on 20 April 2025).
- R Core Team, R. A Language and Environment for Statistical Computing; R Foundation for Statistical Computing: Vienna, Austria, 2022; Available online: https://www.R-project.org/ (accessed on 20 April 2025).
- Fox, J.; Weisberg, S. An R Companion to Applied Regression, 3rd ed.; Sage Publications: New York, NY, USA, 2019; Available online: https://www.john-fox.ca/Companion/ (accessed on 11 April 2025).
- Ogle, D.H.; Doll, J.C.; Wheeler, A.P.; Dinno, A. Simple Fisheries Stock Assessment Methods; R Package FSA Version 0.9.6; CRAN: Vienna, Austria, 2025. [Google Scholar] [CrossRef]
- Spencer, G.; Hans-Peter, P.; Luciano, S.; Sundar, D.-R. MultcompView: Visualizations of Paired Comparisons; Version 0.1-10; CRAN: Vienna, Austria, 2006. [Google Scholar] [CrossRef]
- Wayne, L.G.; Brenner, D.J.; Colwell, R.R.; Grimont, P.A.D.; Kandler, O.; Krichevsky, M.I.; Moore, L.H.; Moore, W.E.C.; Murray, R.G.E.; Stackebrandt, E.; et al. Report of the Ad Hoc Committee on Reconciliation of Approaches to Bacterial Systematics. Int. J. Syst. Evol. Microbiol. 1987, 37, 463–464. [Google Scholar] [CrossRef]
- Meschke, H.; Walter, S.; Schrempf, H. Characterization and Localization of Prodiginines from Streptomyces lividans Suppressing Verticillium dahliae in the Absence or Presence of Arabidopsis thaliana. Environ. Microbiol. 2012, 14, 940–952. [Google Scholar] [CrossRef]
- Ramarajan, M.; Devilla, R.; Dow, L.; Walsh, N.; Mead, O.; Zakeel, M.C.M.; Gallart, M.; Richardson, A.E.; Thatcher, L.F. Genomic and Untargeted Metabolomic Analysis of Secondary Metabolites in the Streptomyces griseoaurantiacus Strain MH191 Shows Media-Based Dependency for the Production of Bioactive Compounds with Potential Antifungal Activity. J. Agric. Food Chem. 2024, 72, 24432–24448. [Google Scholar] [CrossRef]
- Liu, S.; Xu, M.; Zhang, H.; Qi, H.; Zhang, J.; Liu, C.; Wang, J.; Xiang, W.; Wang, X. New Cytotoxic Spectinabilin Derivative from Ant-Associated Streptomyces sp. 1H-GS5. J. Antibiot. 2016, 69, 128–131. [Google Scholar] [CrossRef]
- Li Xia, F.; Zheng Yan, G.; Wen Jun, W. Isolation and Characterization of Streptomyces alboflavus SC11 Producing Desertomycin A. Afr. J. Microbiol. Res. 2013, 7, 1246–1252. [Google Scholar] [CrossRef]
- Sheehan, J.; Murphy, C.D.; Caffrey, P. New Insights into Polyene Macrolide Biosynthesis in Couchioplanes caeruleus. Mol. Biosyst. 2017, 13, 866–873. [Google Scholar] [CrossRef]
- Zhang, D.; Lu, Y.; Chen, H.; Wu, C.; Zhang, H.; Chen, L.; Chen, X. Antifungal Peptides Produced by Actinomycetes and Their Biological Activities against Plant Diseases. J. Antibiot. 2020, 73, 265–282. [Google Scholar] [CrossRef]
- Khebizi, N.; Boudjella, H.; Bijani, C.; Bouras, N.; Klenk, H.-P.; Pont, F.; Mathieu, F.; Sabaou, N. Oligomycins A and E, Major Bioactive Secondary Metabolites Produced by Streptomyces sp. Strain HG29 Isolated from a Saharan Soil. J. Mycol. Med. 2018, 28, 150–160. [Google Scholar] [CrossRef] [PubMed]
- Lardy, H.A.; Johnson, D.; McMurray, W.C. Antibiotics as Tools for Metabolic Studies. I. A Survey of Toxic Antibiotics in Respiratory, Phosphorylative and Glycolytic Systems. Arch. Biochem. Biophys. 1958, 78, 587–597. [Google Scholar] [CrossRef]
- Xiao, L.; Niu, H.-J.; Qu, T.-L.; Zhang, X.-F.; Du, F.-Y. Streptomyces sp. FX13 Inhibits Fungicide-Resistant Botrytis Cinerea in Vitro and in Vivo by Producing Oligomycin A. Pestic. Biochem. Physiol. 2021, 175, 104834. [Google Scholar] [CrossRef] [PubMed]
- Zakalyukina, Y.V.; Alferova, V.A.; Nikandrova, A.A.; Kiriy, A.R.; Chernyshova, A.P.; Kabilov, M.R.; Baturina, O.A.; Biryukov, M.V.; Sergiev, P.V.; Lukianov, D.A. Genomic and Phenotypic Characterization of Streptomyces sirii sp. Nov., Amicetin-Producing Actinobacteria Isolated from Bamboo Rhizospheric Soil. Microorganisms 2024, 12, 2628. [Google Scholar] [CrossRef]
- Coque, J.J.R.; Álvarez-Pérez, J.M.; Cobos, R.; González-García, S.; Ibáñez, A.M.; Diez Galán, A.; Calvo-Peña, C. Advances in the Control of Phytopathogenic Fungi That Infect Crops through Their Root System. Adv. Appl. Microbiol. 2020, 111, 123–170. [Google Scholar] [CrossRef]
- López-Escudero, F.J.; Mercado-Blanco, J. Verticillium Wilt of Olive: A Case Study to Implement an Integrated Strategy to Control a Soil-Borne Pathogen. Plant Soil. 2011, 344, 1–50. [Google Scholar] [CrossRef]
- Lalucat, J.; Mulet, M.; Gomila, M.; García-Valdés, E. Genomics in Bacterial Taxonomy: Impact on the Genus Pseudomonas. Genes 2020, 11, 139. [Google Scholar] [CrossRef]
- Lu, J.; Huang, Y.; Liu, R.; Liang, Y.; Zhang, H.; Shen, N.; Yang, D.; Jiang, M. Antimicrobial Mechanisms and Antifungal Activity of Compounds Generated by Banana Rhizosphere Pseudomonas aeruginosa Gxun-2 against Fusarium oxysporum f. sp. cubense. Front. Microbiol. 2024, 15, 1456847. [Google Scholar] [CrossRef] [PubMed]
- Ni, H.; Kong, W.-L.; Zhang, Y.; Wu, X.-Q. Effects of Volatile Organic Compounds Produced by Pseudomonas aurantiaca ST-TJ4 against Verticillium dahliae. J. Fungi 2022, 8, 697. [Google Scholar] [CrossRef] [PubMed]
- Rane, M.R.; Sarode, P.D.; Chaudhari, B.L.; Chincholkar, S.B. Exploring Antagonistic Metabolites of Established Biocontrol Agent of Marine Origin. Appl. Biochem. Biotechnol. 2008, 151, 665–675. [Google Scholar] [CrossRef]
- Uri, J.; Békési, I. Flavofungin, a New Crystalline Antifungal Antibiotic: Origin and Biological Properties. Nature 1958, 181, 908. [Google Scholar] [CrossRef] [PubMed]
- Lim, Y.H.; Wong, F.T.; Yeo, W.L.; Ching, K.C.; Lim, Y.W.; Heng, E.; Chen, S.; Tsai, D.; Lauderdale, T.; Shia, K.; et al. Auroramycin: A Potent Antibiotic from Streptomyces roseosporus by CRISPR-Cas9 Activation. ChemBioChem 2018, 19, 1716–1719. [Google Scholar] [CrossRef]
- Cone, M.C.; Yin, X.; Grochowski, L.L.; Parker, M.R.; Zabriskie, T.M. The Blasticidin S Biosynthesis Gene Cluster from Streptomyces griseochromogenes: Sequence Analysis, Organization, and Initial Characterization. ChemBioChem 2003, 4, 821–828. [Google Scholar] [CrossRef]

| Strain | GenBank Accession Numbers | |||||
|---|---|---|---|---|---|---|
| 16S rRNA | atpD | gyrB | recA | rpoB | trpB | |
| HE64 | PQ638391 | PQ654892 | PQ654898 | PQ654886 | PQ654904 | PQ654910 |
| HR9 | PQ638389 | PQ654890 | PQ654896 | PQ654884 | PQ654902 | PQ654908 |
| HR26 | PQ638386 | PQ654887 | PQ654893 | PQ654881 | PQ654899 | PQ654905 |
| HR31 | PQ638390 | PQ654891 | PQ654897 | PQ654885 | PQ654903 | PQ654909 |
| HR40 | PQ638387 | PQ654888 | PQ654894 | PQ654882 | PQ654900 | PQ654906 |
| HR77 | PQ638388 | PQ654889 | PQ654895 | PQ654883 | PQ654901 | PQ654907 |
| Strain | MLSA (Kimura 2-Parameter) Distance * | |||||
|---|---|---|---|---|---|---|
| HE64 | HR9 | HR26 | HR31 | HR40 | HR77 | |
| Streptomyces sp. HE64 | ||||||
| Streptomyces sp. HR9 | 0.1032 | |||||
| Streptomyces sp. HR26 | 0.1033 | 0.1184 | ||||
| Streptomyces sp. HR31 | 0.1105 | 0.1050 | 0.1129 | |||
| Streptomyces sp. HR40 | 0.0663 | 0.1152 | 0.1053 | 0.1123 | ||
| Streptomyces sp. HR77 | 0.0869 | 0.1170 | 0.0829 | 0.1144 | 0.0910 | |
| Streptomyces flavofungini NRRL B12307 | 0.1092 | 0.0958 | 0.0919 | 0.1134 | 0.1144 | 0.0160 |
| Streptomyces luteogriseus NRRL B12422 | 0.0672 | 0.1157 | 0.1048 | 0.1133 | 0.0040 | 0.0901 |
| Streptomyces rectiviolaceus NRRL B16374 | 0.1171 | 0.1214 | 0.0646 | 0.1152 | 0.1125 | 0.0968 |
| Streptomyces robefuscus NRRL B5743 | 0.1034 | 0.0020 | 0.1205 | 0.1164 | 0.1147 | 0.1231 |
| Streptomyces rubiginosohelvolus CGMCC 4.0127 | 0.0329 | 0.1069 | 0.1047 | 0.1086 | 0.0725 | 0.0860 |
| Streptomyces sirii CCTCC AA2024094 | 0.1259 | 0.1156 | 0.1340 | 0.0020 | 0.1276 | 0.1348 |
Disclaimer/Publisher’s Note: The statements, opinions and data contained in all publications are solely those of the individual author(s) and contributor(s) and not of MDPI and/or the editor(s). MDPI and/or the editor(s) disclaim responsibility for any injury to people or property resulting from any ideas, methods, instructions or products referred to in the content. |
© 2025 by the authors. Licensee MDPI, Basel, Switzerland. This article is an open access article distributed under the terms and conditions of the Creative Commons Attribution (CC BY) license (https://creativecommons.org/licenses/by/4.0/).
Share and Cite
Ghoreshizadeh, S.; Calvo-Peña, C.; Ruiz-Muñoz, M.; Dobrajc, M.; Radišek, S.; Coque, J.J.R.; Cobos, R. Isolation and Characterization of Pseudomonas sp. HX1, Streptomyces luteogriseus HR40, and Streptomyces flavofungini HR77 as Promising Biocontrol Agents Against Verticillium Wilt in Hops Affected by Verticillium nonalfalfae. Horticulturae 2025, 11, 459. https://doi.org/10.3390/horticulturae11050459
Ghoreshizadeh S, Calvo-Peña C, Ruiz-Muñoz M, Dobrajc M, Radišek S, Coque JJR, Cobos R. Isolation and Characterization of Pseudomonas sp. HX1, Streptomyces luteogriseus HR40, and Streptomyces flavofungini HR77 as Promising Biocontrol Agents Against Verticillium Wilt in Hops Affected by Verticillium nonalfalfae. Horticulturae. 2025; 11(5):459. https://doi.org/10.3390/horticulturae11050459
Chicago/Turabian StyleGhoreshizadeh, Seyedehtannaz, Carla Calvo-Peña, Marina Ruiz-Muñoz, Maja Dobrajc, Sebastjan Radišek, Juan José R. Coque, and Rebeca Cobos. 2025. "Isolation and Characterization of Pseudomonas sp. HX1, Streptomyces luteogriseus HR40, and Streptomyces flavofungini HR77 as Promising Biocontrol Agents Against Verticillium Wilt in Hops Affected by Verticillium nonalfalfae" Horticulturae 11, no. 5: 459. https://doi.org/10.3390/horticulturae11050459
APA StyleGhoreshizadeh, S., Calvo-Peña, C., Ruiz-Muñoz, M., Dobrajc, M., Radišek, S., Coque, J. J. R., & Cobos, R. (2025). Isolation and Characterization of Pseudomonas sp. HX1, Streptomyces luteogriseus HR40, and Streptomyces flavofungini HR77 as Promising Biocontrol Agents Against Verticillium Wilt in Hops Affected by Verticillium nonalfalfae. Horticulturae, 11(5), 459. https://doi.org/10.3390/horticulturae11050459








